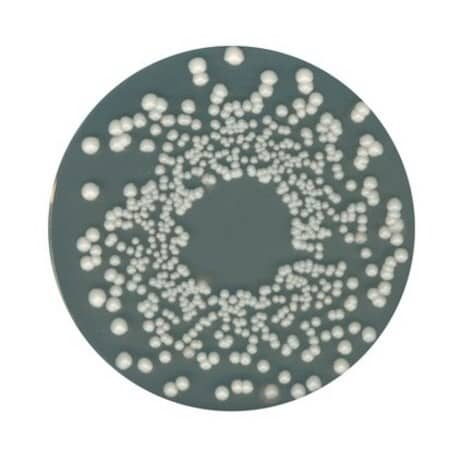
محیط کشت اورنج سرم آگار(OSR)مرک ، کد 110673

محیط کشت اورنج سرم آگار(OSR)مرک ، کد 110673
دستهبندیها:
نام محصول
محیط کشت اورنج سرم آگار(OSR)مرک ، کد 110673
شناسه محصول
110673
برند
Catalouge Number
110673
مقدار
500gr
Packaging
Plastic bottle
pH value
5.4 - 5.6 (42 g/l, H₂O, 37 °C) (after autoclaving)
Bulk density
700 kg/m3
application(s)
food and beverages, microbiology
Storage
Store at +15°C to +25°C.
Solubility
42 g/l
technique(s)
microbiological culture: suitable
suitability
molds, yeasts
agency
according to IFU
form
medium granules (dehydrated (DCM))
با توجه به نوسانات بازار، قیمت محصولات در حال تغییر میباشد. برای استعلام دقیق قیمت، با ما تماس بگیرید.
ریال148.000.000
آخرین بروزرسانی 2 ماه پیش
ریال148.000.000

دیدگاهها
هیچ دیدگاهی برای این محصول نوشته نشده است.